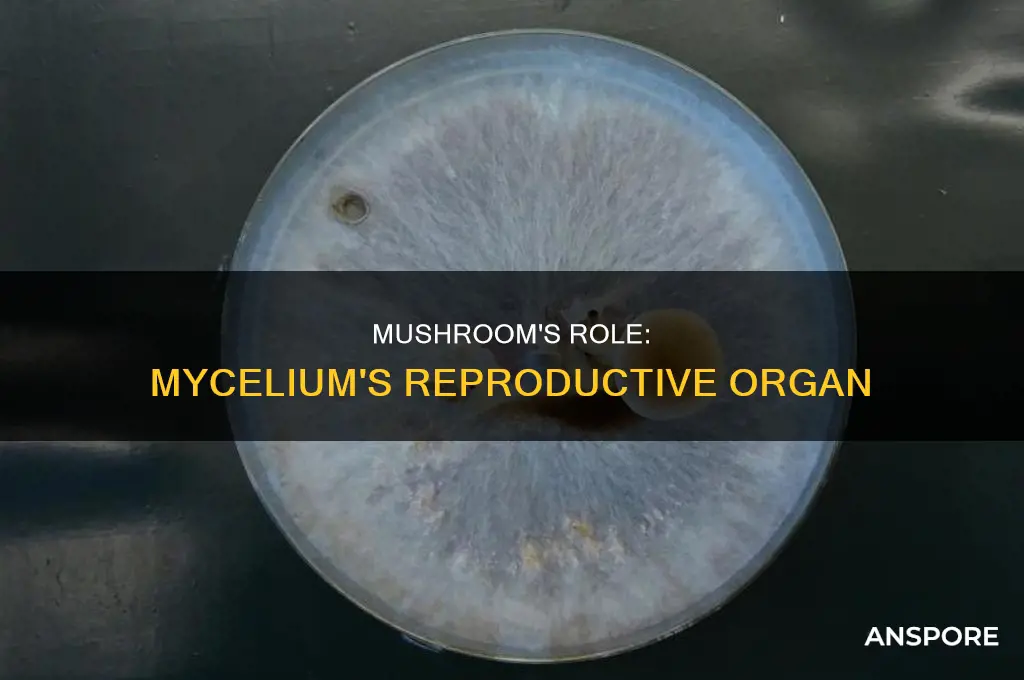
are mushrooms reproductive organs of mycelium

Mushrooms are the reproductive organs of mycelium, which is the vegetative part of a fungus that grows and expands underground to absorb nutrients. Fungi have evolved unique mechanisms for reproduction, including both sexual and asexual methods. The majority of fungi reproduce asexually by forming spores, which can be dispersed to form new colonies. Some fungi also reproduce asexually through budding, where a small outgrowth from the parent fungus develops into a new individual. Sexual reproduction in fungi involves the fusion of two nuclei from different sex cells (gametes) to form seeds or spores, which are then dispersed to grow into new colonies. Fungi have complex mating systems, with some species exhibiting homothallism (self-fertility) and others requiring interaction with a compatible individual (heterothallism). The ability to reproduce both sexually and asexually allows mushrooms to rapidly colonize new areas and adapt to changing environmental conditions.
| Characteristics | Values |
|---|---|
| Are mushrooms reproductive organs? | Mushrooms are the reproductive organs of mycelium, the vegetative part of the fungus that spreads underground and absorbs nutrients. |
| How do mushrooms reproduce? | Mushrooms reproduce through a combination of asexual and sexual mechanisms. |
| Asexual reproduction | Fragmentation of the mycelium, budding, fission |
| Sexual reproduction | Formation of "seeds" known as spores, which are dispersed to new locations where they germinate and grow into new colonies |
| Mating types | Homothallism, heterothallism |
Explore related products
What You'll Learn

Sexual reproduction in mushrooms
Mushrooms are the reproductive organs of mycelium, the vegetative part of the fungus that spreads underground and absorbs nutrients. Fungi have evolved unique mechanisms for reproduction, including both sexual and asexual methods.
Mushrooms can reproduce sexually by producing "seeds" called spores, which are formed in structures called fruiting bodies. These spores are typically dispersed by wind, water, or other means to new locations, where they can germinate and form new colonies. Sexual reproduction in mushrooms usually occurs when the environment becomes less favorable, often at the end of the growing season.
The process of sexual reproduction in mushrooms involves the fusion of two nuclei. This occurs when two sex cells (gametes) unite, resulting in the formation of haploid spores. The fusion of two haploid nuclei then leads to the formation of the diploid mycelium. This life cycle allows for genetic recombination, enabling the fungus to adapt to changing environmental conditions and resist diseases.
During sexual reproduction, mushrooms release pheromones to attract potential mates. When two compatible mycelia meet, they communicate to establish a reproductive partnership. This communication allows them to negotiate their relationship and determine whether to fuse or remain independent.
While sexual reproduction requires more time and energy compared to asexual reproduction, it offers the advantage of genetic diversity in the offspring. This increases the chances of survival in changing environments as the offspring inherit a blend of traits, making them distinct from their parents and each other.
Do Mushroom Hunting Glasses Work?
You may want to see also

Asexual reproduction in mushrooms
Mushrooms are the reproductive organs of mycelium, and they reproduce through a combination of asexual and sexual mechanisms. Asexual reproduction in mushrooms occurs through the following methods:
Fragmentation
The mycelium, which is the vegetative part of the fungus that spreads underground and absorbs nutrients, can break into fragments. Each fragment can then grow and become a new mushroom. This process is called mycelial fragmentation.
Budding
Budding is another method of asexual reproduction in mushrooms. It occurs when a small outgrowth or bud develops on the parent fungus. The cytoplasm of the bud is continuous with that of the parent cell. The nucleus of the parent cell then divides, and one of the daughter nuclei migrates into the bud, which eventually detaches and grows into a new individual mushroom.
Spores
Asexual spores are produced by one parent only (through mitosis) and are genetically identical to that parent. They are released either outside or within a special reproductive sac called a sporangium. Spores allow mushrooms to expand their distribution and colonize new environments. A mid-sized mushroom can release up to 20 billion spores over 4-6 days at a rate of 100 million spores per hour.
Oyster Mushrooms: Leathery or Not?
You may want to see also

Spores and their role in mushroom reproduction
Mushrooms are part of the kingdom Fungi, which reproduces through unique mechanisms that include both sexual and asexual methods. Fungi reproduce by forming and releasing spores, which are usually haploid and single-celled. These spores are produced either directly by asexual means or indirectly through sexual reproduction.
Asexual reproduction in mushrooms can occur through the fragmentation of the mycelium, the vegetative part of the fungus that spreads underground and absorbs nutrients. The mycelium can break into fragments, each of which can grow into a new individual. Some mushrooms also reproduce asexually through budding, where a small outgrowth from the parent fungus develops into a new individual mushroom. Asexual spores are genetically identical to the parent and can be released externally or within a special reproductive sac called a sporangium. There are many types of asexual spores, including conidiospores, which are released directly from the tip or side of the hypha, and sporangiospores, which are produced in a sporangium.
Sexual reproduction in mushrooms involves the formation of "seeds," known as spores, within structures called fruiting bodies. These spores are typically dispersed by wind, water, or other means to new locations where they can germinate and grow into new colonies. Sexual reproduction in fungi includes the fusion of two nuclei when two sex cells (gametes) unite. This process, known as karyogamy or "nuclear marriage," results in the formation of a diploid zygote nucleus. The diploid mycelium is then formed by the fusion of two haploid nuclei. This life cycle allows for genetic recombination, enabling the fungus to adapt to changing environmental conditions and resist diseases.
Fungi have evolved various mechanisms for spore release, such as forcible ejection from their reproductive structures, external mechanical forces, and attracting insects to their fruiting structures for dispersal. The spores travel from the mushroom along wind currents, and when they land in a moist place, they germinate. Each spore grows a network of fine threads called hyphae, which release chemicals to digest and absorb nutrients for the growing fungus.
Mushroom Magic: Unlocking Umami in Your Meals
You may want to see also
Explore related products

Fungi's unique life cycle
Fungi are abundant worldwide, but most are inconspicuous due to their small size and cryptic lifestyles in soil or on dead matter. They play a crucial role in decomposing organic matter and have essential roles in nutrient cycling and exchange in the environment. They are also used in food production, the creation of antibiotics, and as biological pesticides.
The life cycle of fungi is unique and complex, involving both sexual and asexual reproduction methods. Fungi can switch between these modes of reproduction depending on environmental conditions. The asexual phase usually precedes the sexual phase and may be repeated frequently before the sexual phase appears. Some fungi differ in that they reproduce only sexually or only asexually.
During the asexual phase, fungi produce spores that can survive harsh environmental conditions. These spores are dispersed and, when they find a suitable environment, begin to germinate and produce a new mycelium. The mycelium then expands and produces new spores, repeating the cycle.
The sexual phase is more complex, involving processes like plasmogamy (fusion of cellular contents), karyogamy (fusion of nuclei), and meiosis (reduction division). In the life cycle of a sexually reproducing fungus, a haploid phase alternates with a diploid phase. The haploid phase involves the production of haploid spores, which occurs through the fusion of gametes. The diploid phase begins with the formation of the zygote (diploid cell resulting from the fusion of two haploid sex cells) and ends with nuclear fusion, initiating the haploid phase.
Fungi have evolved unique mechanisms for reproduction, including sexual and asexual methods. Mushrooms, for example, can reproduce asexually by fragmentation of the mycelium, where each fragment grows into a new individual. They can also reproduce sexually by producing "seeds" (spores) that are dispersed and germinate into new colonies.
Mushroom Sprouting: The Perfect Timing for Growth
You may want to see also

Fungi communication and its impact on reproduction
Mushrooms are the reproductive organs of mycelium, which is the vegetative part of a fungus that spreads and absorbs nutrients. Fungi have evolved unique mechanisms for reproduction, including both sexual and asexual methods.
Fungi Communication
Fungi are able to communicate with a wide range of beings, including many other species. They are constantly sensing, learning, and making decisions. Fungi communicate within their own organism and between fungi of the same species. They also communicate with other organisms, including bacteria, plant cells, and animals. Fungi communicate through chemical and electrical signals. They have branched structures and use some of the same amino acids as nervous systems to transmit information.
Fungi also communicate through pheromones. They send out pheromones and "sniff" out those of others, then grow toward those that seem attractive. When two mycelia meet, they communicate to negotiate their relationship, which can range from fusion to physical exclusion.
Impact on Reproduction
Communication is essential for fungi to mate and reproduce. Fungi that reproduce sexually send out pheromones to find compatible partners. They also communicate through Ste12-like proteins, which are essential for sexual reproduction as they respond to pheromone stimulus and activate mating-specific genes.
Fungi that reproduce asexually also rely on communication to coordinate their growth and development. For example, in budding, a bud develops on the surface of the parent cell, and the nucleus divides, with one daughter nucleus migrating into the bud. Communication is necessary for this process to occur successfully.
Overall, communication plays a crucial role in the reproduction of fungi, allowing them to find mates, coordinate their growth, and respond to their environment.
Mushroom Steaming: Healthy Cooking Method?
You may want to see also
Frequently asked questions
Mushrooms reproduce through a combination of asexual and sexual mechanisms. Asexual reproduction in mushrooms can occur through the fragmentation of the mycelium, the vegetative part of the fungus that spreads underground and absorbs nutrients. Sexual reproduction in mushrooms involves the formation of "seeds" known as spores, which are produced in structures called fruiting bodies.
Spores are typically single cells produced by the fragmentation of the mycelium or within specialised structures. They can be produced either directly by asexual methods or indirectly by sexual reproduction. Spores are dispersed by wind, water, or other means to new locations where they germinate and grow into new colonies.
Asexual reproduction in mushrooms involves the replication of the parent fungus through methods such as budding or fragmentation. Sexual reproduction, on the other hand, involves the fusion of two nuclei from different individuals, resulting in offspring with a blend of traits, making them more adaptable to new environments.
The combination of asexual and sexual reproduction methods allows mushrooms to rapidly colonise new areas and adapt to changing conditions. Different situations call for different reproductive strategies, and having both options available increases the chances of survival for the fungus.

























